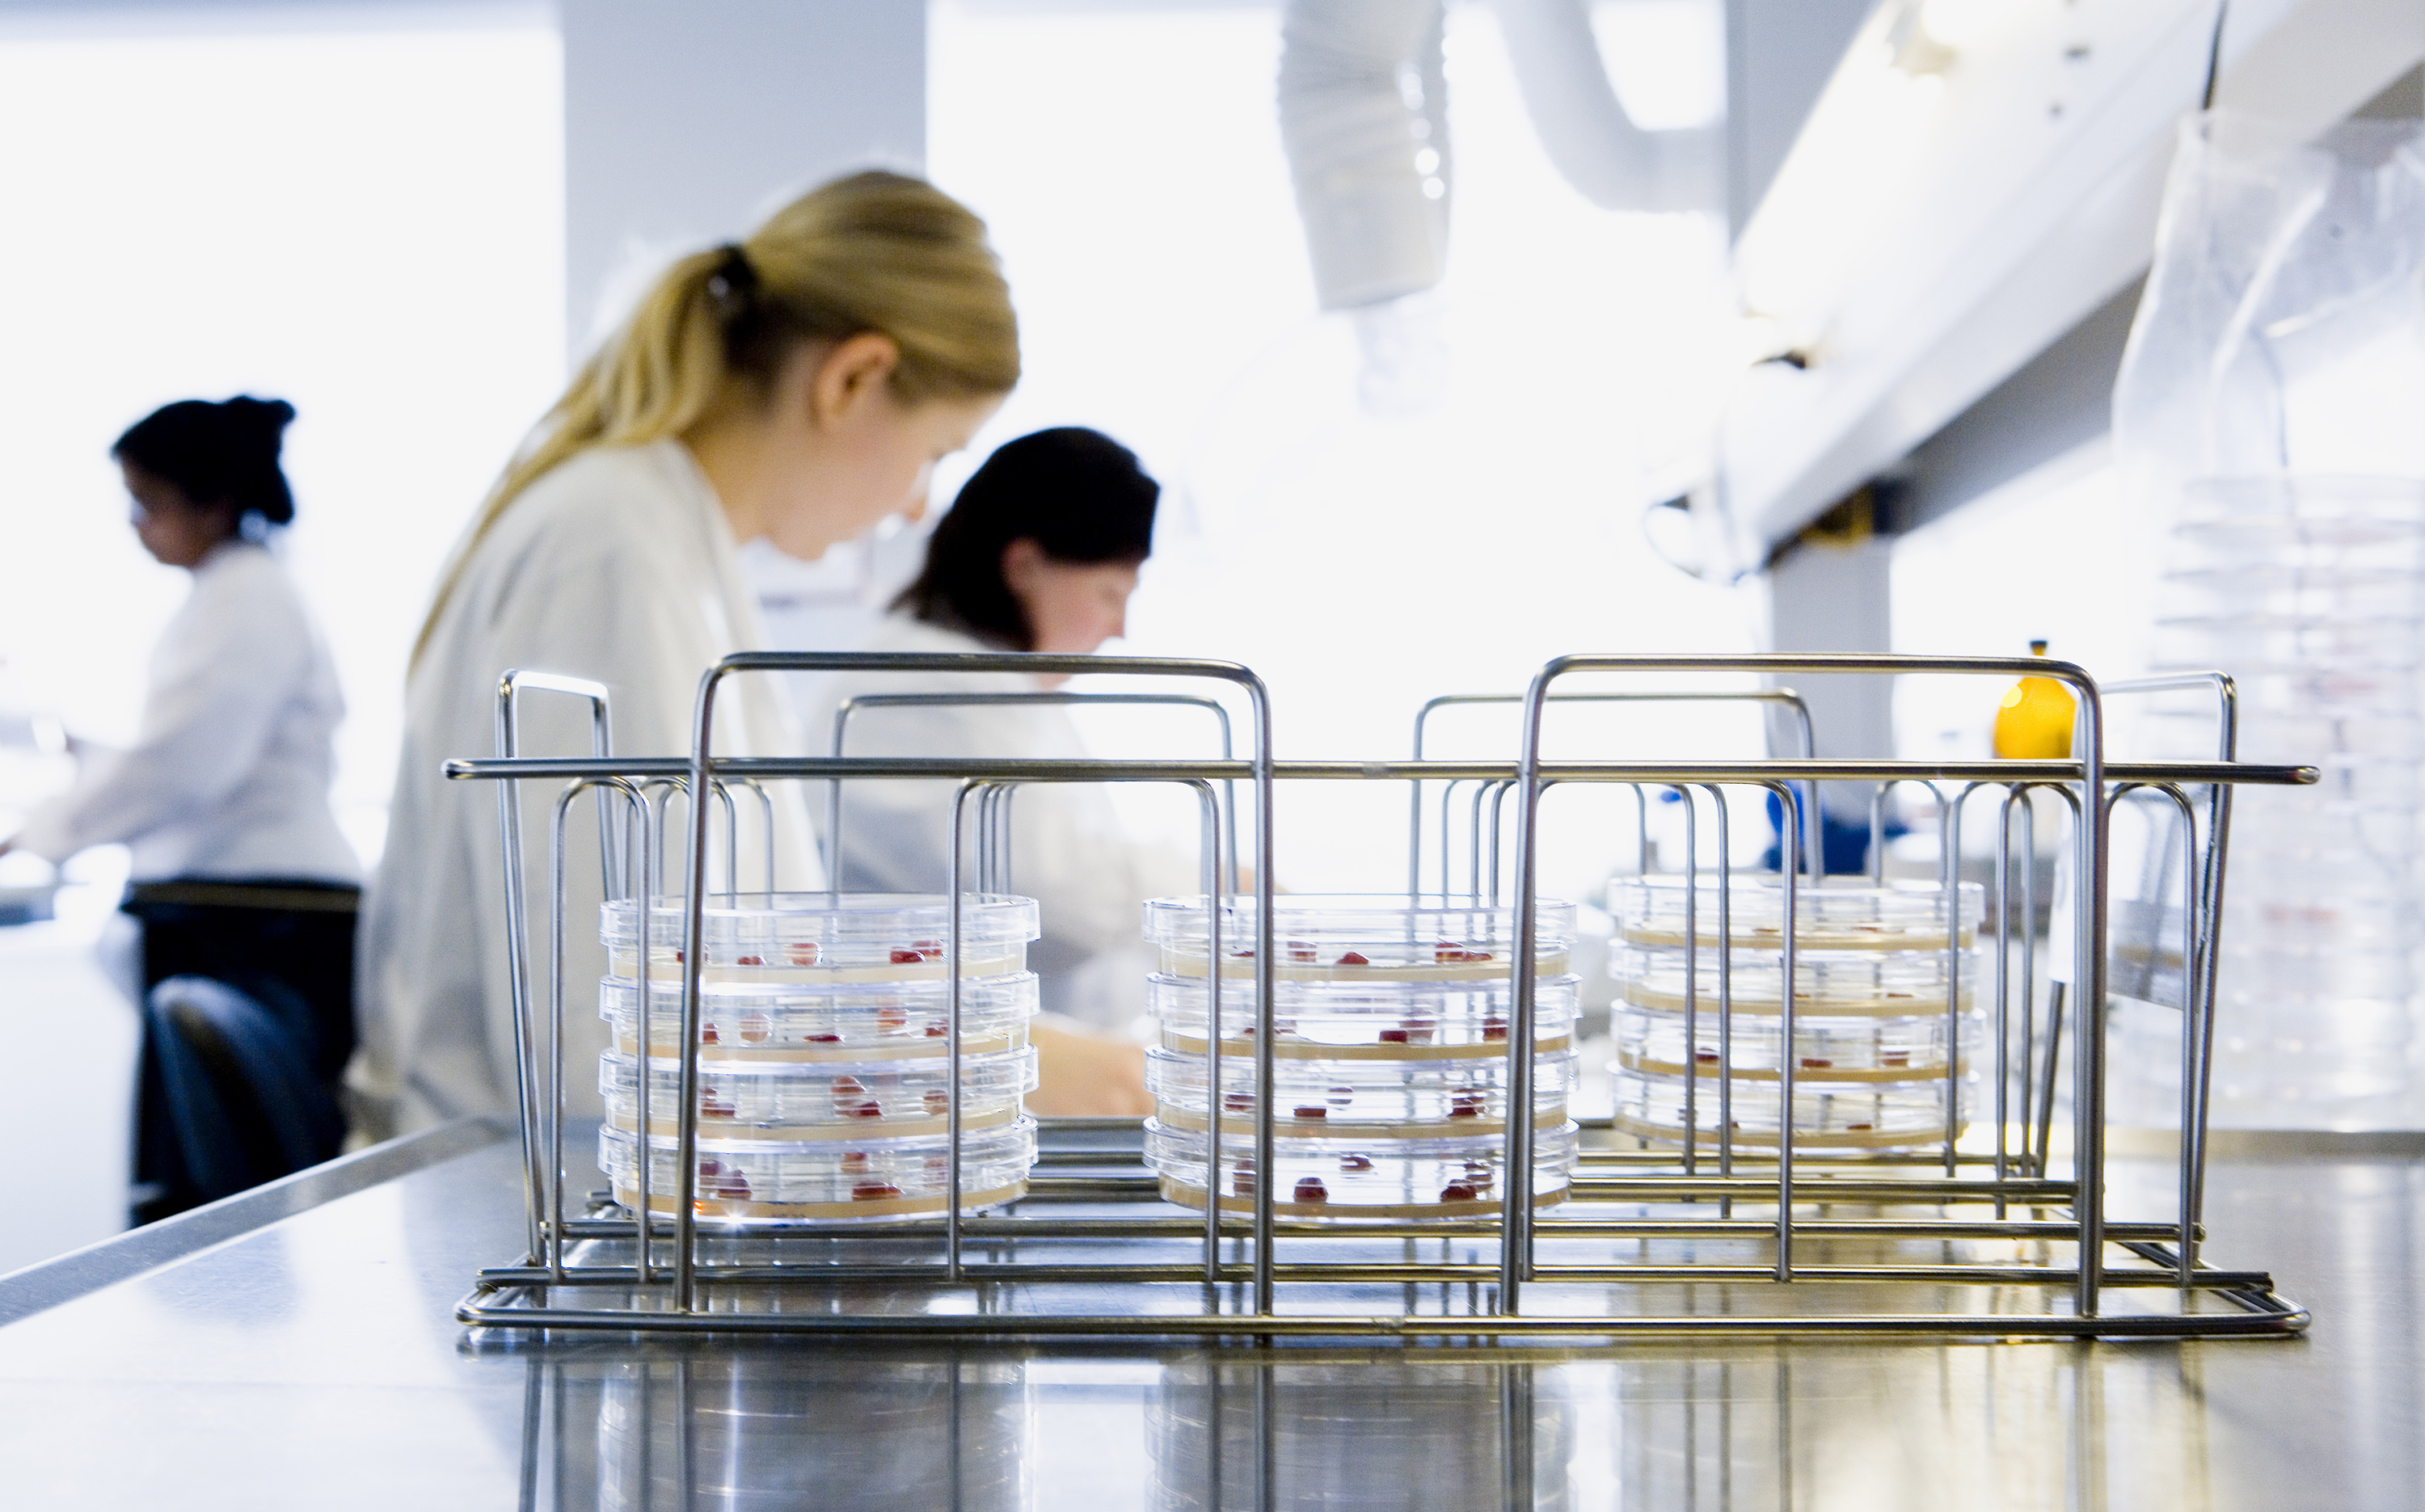
Laboratorium

Laboratoriet er godkendt af Fødevarestyrelsen til at udføre veterinær diagnostik, og vi har været akkrediteret af DANAK siden 2006.

Opdateret/Gennemlæst 17. januar 2022
Laboratoriet er godkendt af Fødevarestyrelsen til at udføre veterinær diagnostik, og vi har været akkrediteret af DANAK siden 2006.
Veterinært Laboratorium, Kjellerup (reg. nr. 470) er akkrediteret til en lang række analyser. Grundlaget for akkrediteringen er den internationale standard DS/EN ISO/IEC 17025.
Akkrediteringen er din sikkerhed for, at prøvningsresultaterne har en høj kvalitet.
For at laboratoriet kan opretholde sin akkreditering, skal det bl.a. opfylde nedenstående krav:
DANAK fører regelmæssigt tilsyn med laboratoriet.
Når du sender prøvemateriale ind til Veterinært Laboratorium, Kjellerup, accepterer man automatisk Veterinært Laboratorium, Kjellerups, ansvarsregulering.
Svar på diagnostiske spørgsmål afgives skriftligt. Til skrift henregnes telefax og e-post.
Delsvar eller mundtlige svar på diagnostiske spørgsmål er at anse som foreløbige svar og er derfor angivet uden ansvar for LANDBRUG & FØDEVARER F.M.B.A.
Ved laboratoriefejl forstås i nærværende regelsæt fejl begået af LANDBRUG & FØDEVARER F.M.B.A. i forbindelse med modtagelsen og undersøgelsen af prøvemateriale og besvarelsen af diagnostiske spørgsmål.
LANDBRUG & FØDEVARER F.M.B.A. er kun ansvarlig for laboratoriefejl, hvis det godtgøres, at fejlen alene skyldes forsømmelser fra LANDBRUG & FØDEVARER F.M.B.A.'s side.
LANDBRUG & FØDEVARER F.M.B.A.'s ansvar omfatter kun tab ved de skader, der direkte er forårsaget af de laboratoriefejl, LANDBRUG & FØDEVARER F.M.B.A. er ansvarlige for, det vil sige udgifter til fremskaffelse og indsendelse af nyt prøvemateriale og ny laboratorieundersøgelse.
Som direkte skade betragtes endvidere omkostninger og tab ved aflivning af dyr solgt fra den besætning, hvorfra det undersøgte prøvemateriale er indsendt som følge af laboratoriefejlen.
I de tilfælde, hvor der kan fremsættes erstatningskrav mod LANDBRUG & FØDEVARER F.M.B.A., erstattes indirekte tab ikke.
Som direkte tab anses til eksempel - men ikke udelukkende - driftstab, avancetab eller tab, som er lidt som følge af dispositioner, der er foretaget eller undladt på grund af det fejlagtige laboratorieansvar.
LANDBRUG & FØDEVARER F.M.B.A. er ikke ansvarlig for laboratoriefejl over for andre end indsenderen af prøvemateriale, rekvirenten af den diagnostiske undersøgelse eller den direkte modtager af det fejlagtige laboratoriesvar.
LANDBRUG & FØDEVARER F.M.B.A.'s ansvar er under alle omstændigheder begrænset beløbsmæssigt, således at erstatning aldrig kan overstige fem gange det honorar, som er aftalt for den pågældende opgave.
LANDBRUG & FØDEVARER F.M.B.A. er ikke ansvarlig for diagnostiske svar, der afgives forsinket i forhold til tidligere tilkendegivelser eller tidligere praksis.
LANDBRUG & FØDEVARER F.M.B.A.'s ansvar er betinget af, at den erstatningsberettigede giver LANDBRUG & FØDEVARER F.M.B.A. meddelelse om sit krav senest 8 dage efter det tidspunkt, hvor den pågældende har opdaget eller burde have opdaget fejlen.
LANDBRUG & FØDEVARER F.M.B.A. hæfter kun i 12 måneder efter udsendelse af det fejlagtige diagnostiske svar.
Tvister om ansvar for laboratoriefejl afgøres endelig af DanBred-Voldgiftsretten.
Tvisten afgøres i overensstemmelse med ret og billighed og under anvendelse af "Regler for DanBred-Voldgiftsretten".
LANDBRUG & FØDEVARER F.M.B.A. modtager på eget laboratorium prøvemateriale, der undersøges med henblik på besvarelse af diagnostiske spørgsmål.
Prøvematerialet indsendes fra besætninger, der er identificeret ved CHR-numre eller anden éntydig identifikation.
Nærværende regelsæt finder anvendelse, hvis der opstår tvist om ansvaret for laboratoriefejl mellem indsenderen af prøvematerialet, rekvirenten af den diagnostiske undersøgelse og/eller modtageren af det diagnostiske svar af LANDBRUG & FØDEVARER F.M.B.A.
Du er altid velkommen til at kontakte Veterinært Laboratorium, Kjellerup, hvis du har spørgsmål til vores undersøgelser eller til indsendelse/aflevering af dyr eller andet prøvemateriale. Alle undersøgelser udføres efter aftale og i samarbejde med den praktiserende dyrlæge i besætningen.
Laboratoriet kan kontaktes på tlf. 3339 4950 eller på labkjellerup@lf.dk.
Adressen er:
Vinkelvej 13
8620 Kjellerup
Åbningstider er:
Printet er fra Svineproduktion.dk. d. 13-01-2026
Ophavsretten tilhører Landbrug & Fødevarer Sektor for Gris. Informationerne fra denne hjemmeside må anvendes i anden sammenhæng med kildeangivelse.
Ansvar: Informationerne på denne side er af generel karakter og søger ikke at løse individuelle eller konkrete rådgivningsbehov. Landbrug & Fødevarer Sektor for Gris er således i intet tilfælde ansvarlig for tab, direkte såvel som indirekte, som brugere måtte lide ved at anvende de indlagte informationer.
Artiklen findes på adressen: svineproduktion.dk/Services/Laboratoriet/Om-Laboratoriet/Kontakt